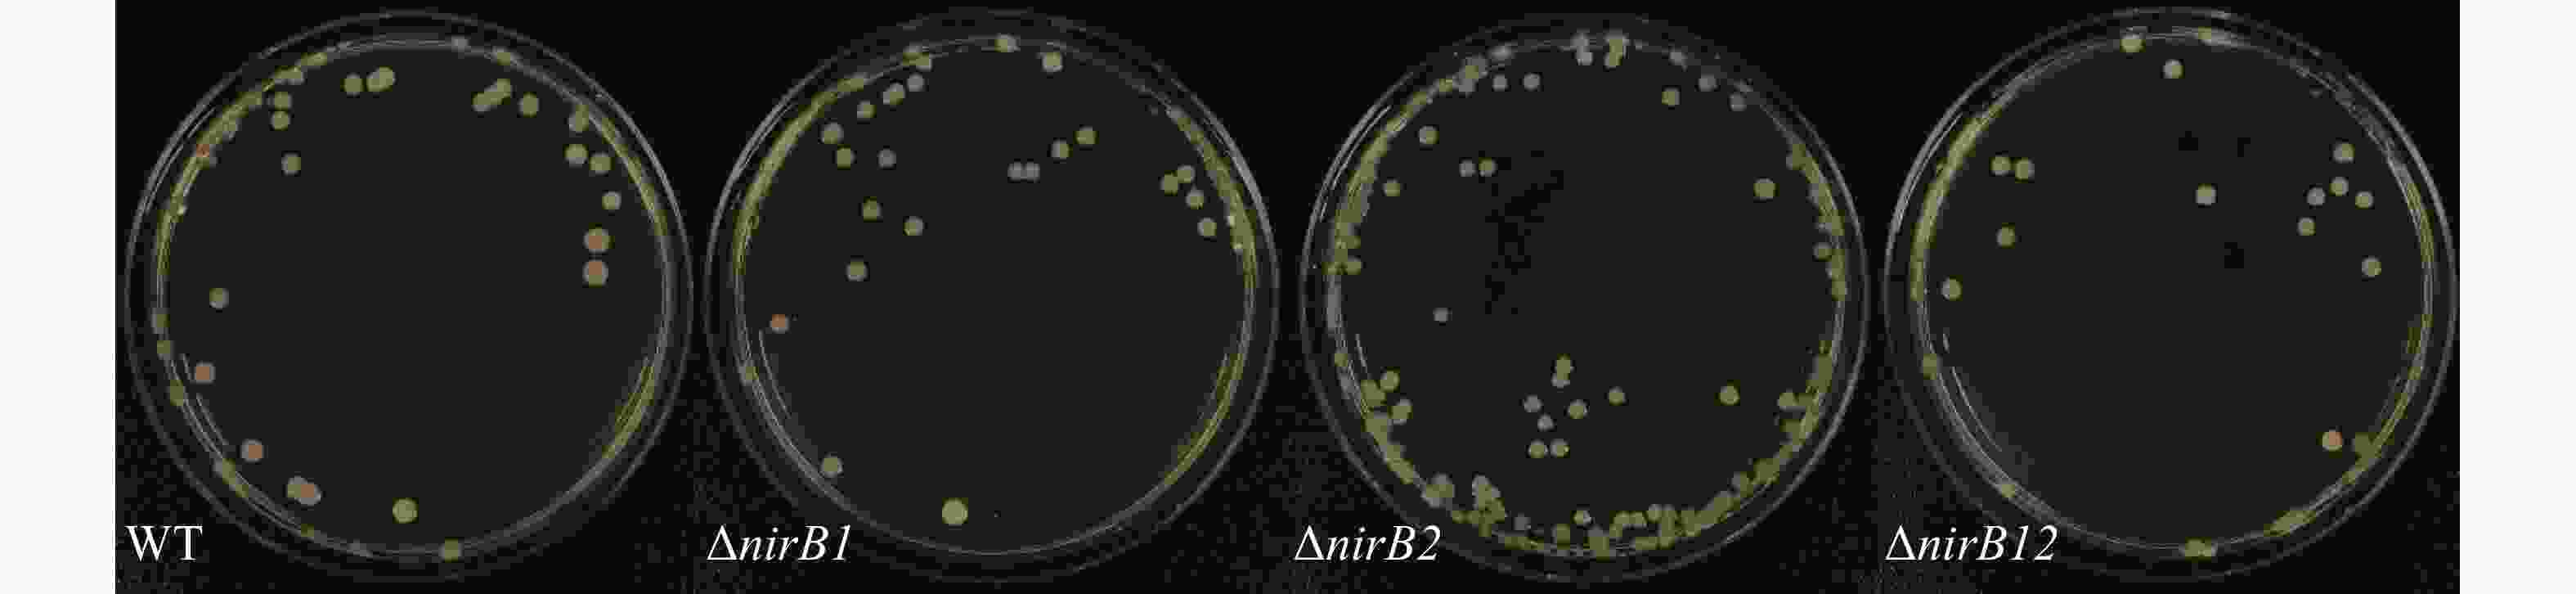

-
溶藻弧菌(Vibrio alginolyticus)属弧菌科(Vibrionaceae)、弧菌属(Vibiro)。具有氨苄抗性,是一种海生嗜盐性、嗜温性弧菌,革兰氏染色呈阴性,具有端鞭毛和侧鞭毛,能在液体和固体培养基上移动。是水产品中的一种常见致病性弧菌,能引发细菌性出血等疾病,被溶藻弧菌感染的鱼、虾死亡率较高[1]。溶藻弧菌能够利用多种氮源进行生长,包括铵盐、硝酸盐和亚硝酸盐等无机氮源,以及部分有机氮源[2]。在利用硝酸和亚硝酸方面,溶藻弧菌展现出其独特的代谢能力。硝酸和亚硝酸是氮循环中的重要中间产物,生物体能够通过特定的酶系统将它们转化为自身可利用的氮源,从而满足其生长和繁殖的需求[3]。
细菌利用硝酸和亚硝酸的能力与nir族基因密切相关。亚硝酸还原酶在氮循环过程中起着重要的作用,nirB基因参与编码该酶,促进亚硝酸盐(NO2−)转变成(NH4+);而nirS和nirK基因则分别编码cd1型亚硝酸还原酶和Cu型亚硝酸还原酶,这两种酶在反硝化过程中起限速作用,将NO2−还原为一氧化氮(NO)[4]。现有研究发现nirB基因与氮代谢途径有着密切的关系[5-7]。nirB 基因编码的同化亚硝酸还原酶参与氮循环过程中,同时nirB基因与硝酸盐的利用也存在密切的关系,在硝酸盐异化还原为铵(DNRA)过程中起着关键作用[8-9]。不同的nirB基因在不同的菌功能存在差异,但目前主要研究是关于nirB基因参与NO3−还原为铵盐(NH4+)[10],但这一过程是直接将NO3−还原成NH4+还是先将NO3-还原成NO2−再还原成NH4+,这一机制尚未研究透彻,而在一些含有nirB基因的反硝化细菌中,nirB基因编码的亚硝酸盐还原酶是反硝化过程的关键酶之一[11],参与将NO2−还原为NO。有相关报道发现,nirB基因相对独立,与其他基因的关联性不大[12],因此在研究nirB基因功能时,能更少受到其他基因影响。
溶藻弧菌作为水产养殖中引发高死亡率病害的重要致病菌,其对硝酸盐、亚硝酸盐等氮源的利用影响菌体在环境中的存活、繁殖及致病潜力。nirB是其氮代谢通路中已鉴定的亚硝酸还原酶编码基因,但目前尚无关于溶藻弧菌nirB基因的功能的研究;且溶藻弧菌缺乏nirK/S基因的独特遗传背景,使nirB功能更具“独立性”,是研究氮代谢的理想靶点。本实验室在前期研究中分离鉴定到1株致病性溶藻弧菌HN08155,经基因组测序分析发现其中含有2个nirB基因,其编码蛋白(EC1.7.1.15)经KEGG代谢通路分析也与亚硝酸盐代谢直接相关(图1)。鉴于此,本研究聚焦溶藻弧菌2个nirB基因在铵盐、硝酸盐、亚硝酸盐等常见氮源代谢过程中的功能,既能填补溶藻弧菌氮代谢分子机制的空白,又能为解析其通过氮源适应增强环境竞争力的策略、开发针对性防控手段提供理论依据,对深入理解溶藻弧菌的环境适应性及致病机制具有重要意义。
-
本实验菌株为实验室保存的溶藻弧菌HN08155,全基因组数据已上传至NBCI(Accession Number: SRR35782836)。利用同源重组的原理,通过pDM4自杀质粒成功构建HN08155的nirB1基因缺失株(ΔnirB1)、nirB2基因缺失株(ΔnirB2),以及nirB1和nirB2基因双缺失株(ΔnirB12)。
-
(1)铵盐培养基(M9培养基):将6.78 g NaH2PO4、3.0 g KH2PO4、20 g NaCL、1.0 g NH4CL、4.0 g 葡萄糖溶于1 L纯水中,115℃灭菌15 min。待培养基温度降至50 ~60℃ 后,按100∶1的比例加入121℃灭菌20 min过的质量浓度为49.3 g·L−1 的MgSO4·7H2O和质量浓度为1.1 g·L·1 的CaCL2·6H2O。(2)硝酸盐培养基:M9培养基中,用1 g NaNo3替换唯一的氮源1 g NH4CL,其他不变。(3)铵盐和硝酸盐混合培养基:M9培养基中,用0.5 g NH4CL和0.5 g NaNo3替换唯一的氮源1 g NH4CL,其他不变。(4)亚硝酸盐培养基:M9培养基中,分别用1 g NaNo2、0.5 g NaNo2和0.25 g NaNo2替换唯一的氮源1 g NH4CL,其他不变。配制出3种不同质量浓度的亚硝酸盐培养基。(5)铵盐和亚硝酸盐混合培养基:在含有1 g NH4CL为唯一氮源的M9培养基的基础上分别添加1 g NaNo2、0.5 g NaNo2和0.25 g NaNo2,配制出3种不同质量浓度的铵盐和亚硝酸盐混合培养基。(6)硝酸盐肉汤培养基:购自青岛高科技工业园海博生物技术有限公司。(7)LBS培养基:将10.0 g 胰蛋白胨、30.0 g NaCL、5.0 g 酵母、17.0 g 琼脂粉溶于1 L纯水中,121℃灭菌20 min。
-
(1)硝酸盐还原试剂盒:购自青岛高科技工业园海博生物技术有限公司。(2)E.Z.N.A.® Gel Extraction Kit:购自Omega(美国)。(3)E.Z.N.A.® Plasmid Mini Kit I:购自Omega(美国)。(4)TIANGEN试剂盒(DNA提取):购自北京天根生化科技有限公司。(5)苯酚-硝普钠溶液:称取1.15 g C6H5OH和0.16 g Na2Fe(Cn)5NO·2H2O,溶于100 mL超纯水中。(6)碱性氯溶液:称取14.0 g Na3C6H5O7·2H2O、1.1 g NaOH和0.2 g C3CL2N3NaO3,溶于100 mL超纯水中。(7)还原剂:将10 g·L−1 VCL3溶液、40 g·L−1 SUL溶液、1.0 g·L−1 NED溶液按5∶1∶1比例混合。(8)显色剂:量取50 mL水、10 mL磷酸于烧杯中,加入4.0 g C6H8N2O2S固体,再加入0.20 g C12H14N2·2HCL,充分溶解混合后转移至加100 mL容量瓶中,定容至刻度线。
-
利用HN08155全基因组序列中的nirB基因为模板设计上游/下游同源臂PCR引物(表1)。利用引物nirB-AF+BR、nirB-CF+DR分别扩增nirB基因上下游片段。 随后利用重叠PCR扩增出缺失nirB基因的上下游连接片段,并将PCR产物插入到自杀质粒pDM4中,构建敲除质粒pDM4-nirB。将敲除质粒pDM4-nirB接合转移至野生型溶藻弧菌(WT)。在蔗糖培养条件下,筛选nirB基因缺失株。利用 nirB-TF+TR(表1)引物分别进行验证,在构建成功的单基因缺失菌株上重复上述步骤,从而构建双基因缺失株。
引物
Primers序列
SequencenirB1-TF AGTGGTGTTCCAAAACCATT nirB1-TR GTCTGGGGCGGACATTTAAT nirB1-AF TGCTCTAGAGTATGAAGCAGCGAGTCGGCA nirB1-BR CTGACCGCGCACACGTTGGTAGATGTGGCTCAATGCGTTCTT nirB1-CF AAGAACGCATTGAGCCACATCTACCAACGTGTGCGCGGTCAG nirB1-DR TCCCCCGGGCCATACTGTGCTATCTCTGGA nirB2-TF TTTATCCAACAAAGCCGTGA nirB2-TR TAATTTTCGCTTCACCCACG nirB2-AF CATGCATGCTTCTAGTCTTTATAGTGCGAC nirB2-BR GATGTCGCCTTTCGCTTCAGGGTGCCCTACCATACCGTTACC nirB2-CF GGTAACGGTATGGTAGGGCACCCTGAAGCGAAAGGCGACATC nirB2-DR TCCCCCGGGAGATGACGCTTGGAAAGCCTT pDM4-TF CACAGGAACACTTAACGGCT pDM4-TR TCCTGTTCAGCTACTGACGG Table 1. Primers used in PCR
-
从实验室−80℃冰箱中取出菌株活化培养过夜。取10 μL活化后的菌液在LBS固体培养基上进行划板,连续传代10次后随机挑取单菌落进行PCR验证;将活化后的菌液稀释10−6倍后取100 μL涂布在LBS固体培养基和M9固体培养基上观察其形态。
-
从实验室−80℃冰箱中取出待测菌株活化培养过夜。取100 μL过夜摇的菌液加入到20 mL不加抗生素的M9液体培养基中,转摇至OD600=0.6,离心,弃上清,使用纯水重悬3次,并调整至OD600=0.6。按1∶200接种量分别接种到新鲜的铵盐培养基(M9培养基)、硝酸盐培养基、铵盐和硝酸盐混合培养基、亚硝酸盐培养基、铵盐和亚硝酸盐混合培养基中,分别取稀释菌液到96孔板中,每孔200 μL,每种菌株5组平行。将96孔板放进酶标仪,180 r·min−1、30℃ 震荡培养48 h,酶标仪每隔30 min自动测定孔液OD600。培养结束后,以时间作为横坐标,每孔菌液OD600值作为纵坐标,生成生长曲线并分析其生长特征。
-
从实验室−80℃冰箱中取出待测菌株活化培养过夜。取100 μL活化后的菌液加入到20 mL不加抗生素的M9液体培养基中转摇至OD600=0.6,离心弃上清,菌体使用无菌纯水重悬3次。分别取纯水重悬过的菌液50 μL滴到硝酸盐肉汤培养基后于30℃培养箱中静置培养18~24 h,分别加入硝酸盐还原试剂盒中的溶液A和溶液B各2~3滴。若培养基变红,则证明菌株可以利用硝酸盐转化成亚硝酸盐;若溶液未变红则说明溶液中无亚硝酸盐的存在,此时加入锌条,等待15~20 min,若溶液变红则说明硝酸盐肉汤培养基中仍存在硝酸盐。
-
将各菌株在铵盐/硝酸盐培养基中培养,分别在0、24 h测定其NH4+、NO2−的含量。NH4+的含量用靛酚蓝法测定:将样品稀释到合适的倍数取600 μL 加100 μL苯酚-硝普钠溶液,混匀后加入100 μL 碱性氯溶液,混匀后静置10 min,取200 μL 加入96孔板中在630 nm测定吸光值。NO2−的含量用N-(1-萘基)-乙二胺分光光度法测定:将样品稀释到合适的倍数,取800 μL ,加16 μL显色剂,混匀后静置20 min,取200 μL ,加入96孔板中,在540 nm测定吸光值。分别配置已知NH4+、NO2−含量的标准试剂,绘制标准曲线。
-
单菌落PCR结果表明,HN08155菌株中的带nirB1完整基因的上下游条带在4 000 bp左右,nirB1基因缺失菌株条带在
1200 bp左右,HN08155菌株中的带nirB2完整基因的上下游条带在4 000 bp左右,nirB2基因缺失菌株条带在1 200 bp左右(图2),将PCR产物纯化回收送测,测序结果证明正确。构建成功的基因缺失菌株分别命名为△nirB1、△nirB2、△nirB12。 -
野生株与nirB基因缺失株连续传代10次后随机挑取3个单菌落利用对应的引物验证,单菌落PCR结果均与基因缺失株条带吻合,说明 nirB基因缺失株的遗传稳定(图3)。
-
nirB基因缺失株的与野生株的形态一致:均为圆形、半透明、表面和边缘光滑的黄色菌落,直径2 ~3 mm,结果(图4)表明,nirB基因的缺失对溶藻弧菌的形态无直接影响。
-
ΔnirB1、ΔnirB2、ΔnirB12缺失株在铵盐培养基中培养时,与WT株的生长情况有着较大的区别。ΔnirB2缺失株的OD600在14 h达到峰值,ΔnirB1、 ΔnirB12缺失株的OD600nm在16 h到达峰值,且此时的OD600均比WT株要高,但在达到峰值后便直接进入衰亡期,而WT经过几个小时滞后期后随即进入生长期(图5)。nirB基因的敲除株的细胞密度均比WT的要低,表明溶藻弧菌中nirB基因对其利用铵盐的过程起促进作用。
-
ΔnirB1、ΔnirB12缺失株在铵盐培养基中培养时,与WT株的生长情况有着较大的区别。WT株在0~10 h内生长速度最快,细胞密度在10 h达到峰值,ΔnirB1、ΔnirB2、ΔnirB12缺失株在10~12 h内到达峰值。ΔnirB2缺失株在10-14 h内生长速度较慢与WT株,且峰值比WT株低,ΔnirB1、ΔnirB12缺失株生长速度一直低于WT株,且在10~12 h达到峰值后直接进入衰亡期,OD600最大值仅在0.3左右(图6)。结果表明nirB基因在溶藻弧菌利用硝酸盐过程中起着重要的作用,特别是nirB1基因。
-
ΔnirB2、ΔnirB12缺失株在铵盐和硝酸盐混合培养基培养时,与WT株存在明显的差异。ΔnirB1、ΔnirB2缺失株与WT株在18 h细胞密度达到最大值;而ΔnirB12缺失株在20 h细胞密度达到最大值,生长速度最慢。ΔnirB1缺失株的生长曲线值整体趋势与WT株相似,只是OD600值整体略低;ΔnirB2缺失株生长曲线值趋势相似且均明显低于WT株;ΔnirB12缺失株生长曲线值最低于WT株差异最大。在该培养基中,ΔnirB1缺失株的生长能力基本恢复到WT株状态(图7)。说明nirB1基因的缺失虽然影响其对硝酸盐的影响,但硝酸盐的存在不抑制其对铵盐的利用。ΔnirB2较其在硝酸盐培养基中的生长均有下降,表明该培养基中铵盐的存在可能起负调控作用。
-
ΔnirB1、ΔnirB2、ΔnirB12缺失株在浓度1 g·L−1的亚硝酸盐培养基培养时,生长曲线与WT株无明显差异;在浓度0.5 g·L−1的亚硝酸盐培养基培养时,生长曲线均比WT株略低,但差值较小,可忽略不计;在质量浓度0.25 g·L−1的亚硝酸盐培养基培养时,ΔnirB1、ΔnirB2、ΔnirB12缺失株与WT株的生长曲线均有明显区别,WT株生长迅速,在较短时间内进入对数生长期,细胞密度快速上升,并在48 h内达到较高水平。相比之下,ΔnirB1、ΔnirB2和ΔnirB12这3种缺失株的生长速度明显慢于WT株。ΔnirB1缺失株细胞密度虽随时间有所增加,但始终低于WT株;ΔnirB2缺失株的生长情况与ΔnirB1缺失株类似,但细胞密度整体更低;ΔnirB12缺失株的生长则更为缓慢,细胞密度在48 h内维持在较低水平(图8)。
-
ΔnirB1、ΔnirB2、ΔnirB12缺失株在铵盐和亚硝酸盐质量浓度均为1.0 g·L−1的混合液体培养基中培养时,这些菌株的生长曲线值均比WT株的生长曲线值略高,但都均低于0.2,不能正常生长;在铵盐(质量浓度为1.0 g·L−1)和亚硝酸盐(质量浓度为0.5 g·L−1)的混合液体培养基中培养时,这些菌株的生长曲线与WT相似,细胞密度值处于较低的状态。这些不同菌株在铵盐(质量浓度为1.0 g·L−1)和亚硝酸盐(质量浓度为0.25 g·L−1)的混合液体培养基中培养时,WT株生长迅速,很快进入对数生长期并达到较高细胞密度;而ΔnirB2和ΔnirB12两种缺失株生长明显受抑,生长极为缓慢,细胞密度始终远低于WT株(图9),表明nirB系列基因缺失会显著阻碍溶藻弧菌在铵盐(质量浓度为1.0 g·L−1)和亚硝酸盐(质量浓度为0.25 g·L−1)的混合液体培养基中的生长。
-
WT野生株和ΔnirB2缺失株硝酸盐肉汤培养基在分别加入硝酸盐还原试剂盒中的溶液A和溶液B各2~3滴后培养基变红,说明WT野生株和ΔnirB2缺失株可以利用硝酸盐转化成亚硝酸盐,且ΔnirB2缺失株所生成的红色明显比WT野生株深;ΔnirB1、ΔnirB12缺失株硝酸盐肉汤培养基在分别加入硝酸盐还原试剂盒中的溶液A和溶液B各2~3滴后培养基不变红(图10),说明培养基中不存在亚硝酸盐,加入锌条后,溶液变红,说明培养基中仍存在硝酸盐。
-
分别配置铵盐质量浓度分别为0.05、0.10、0.20、0.30、0.40、0.50 mg·L−1的溶液,按照靛酚蓝法在630 nm测定吸光值,以铵盐质量浓度为纵坐标,吸光值为横坐标绘制标准曲线,结果表明铵盐测定的标准曲线参数为y=2.357 9x−0.005 1(图11);分别配置亚硝酸盐质量浓度分别为0.03、0.06、0.09、0.12、0.15 mg·L−1的溶液,按照N-(1-萘基)-乙二胺分光光度法在540 nm测定吸光值,以亚硝酸盐质量浓度为纵坐标,吸光值为横坐标,绘制标准曲线,结果表明,铵盐测定的标准曲线参数为y=0.817 3x+0.001 4(图12)。
-
利用铵盐培养基(NH4+:337 mg·L−1,NO2−:0 mg·L−1)培养各菌株24h后,培养基中无NO2−积累,NH4+质量浓度均显著下降。培养24 h后WT、ΔnirB1、ΔnirB2和ΔnirB12培养基中NH4+质量浓度分别为60.21、54.55 、79.09 和70.59 mg·L−1(图13-A)。结果表明,2个nirB基因均不参与铵盐的硝化反应,其中nirB1基因也不是溶藻弧菌利用铵盐的必需基因,敲除nirB1后,溶藻弧菌利用铵盐的能力有所增强,结果表明,nirB1基因具有部分负调控铵盐利用的能力。而敲除nirB2基因后,菌株的铵盐利用能力显著下降,表明nirB2基因的存在可以促进铵盐的利用。各菌株在硝酸盐培养基(NO3−:729 mg·L−1,NH4+和NO2−的质量浓度均为0 mg·L−1)中培养24 h时,只有野生株和ΔnirB2能生长,培养24 h后野生株和ΔnirB2培养基中NH4+的质量浓度升高至25.19 和49.47 mg·L−1(图13-B)、野生株和ΔnirB2培养基中NO2−的升高至66.50 和114.89 mg·L−1(图13-C)。结果表明,nirB1是利用硝酸盐的关键基因,其缺失导致细菌无法利用硝酸盐作为氮源;而nirB2则参与亚硝酸盐的进一步代谢,其缺失会引发亚硝酸盐积累增加,其缺失还可能影响溶藻弧菌对的NH4+利用或激活替代途径致铵盐含量增加,或因基因冗余补偿效率低而积累代谢产物。
-
溶藻弧菌中的nirB基因对其形态没有直接影响,但参与与铵盐、硝酸盐、亚硝酸盐等常见氮源代谢。在铵盐培养基中,所有菌株均能正常生长,但不同nirB基因敲除菌株生长能力均比WT株低,说明nirB基因对溶藻弧菌利用铵盐起促进作用,当nirB基因被敲除,nirB基因参与编码的亚硝酸还原酶合成受到影响,进而影响到整个氮代谢通路。在氯化铵作为唯一氮源的培养基中,正常的代谢过程被扰乱,溶藻弧菌不能高效利用氯化铵合成一些其生长必需的物质,如蛋白质、氨基酸等,从而导致nirB缺失株的OD600要低于WT株。目前,尚未有直接证据表明nirB基因直接参与NH4+的吸收或同化过程。在氮的同化过程中,NH4+的吸收和利用主要涉及谷氨酰胺合成酶和谷氨酸合酶等酶,有研究发现nirB基因与谷氨酰胺/谷氨酸的生物合成密切相关[13]。在本研究中,当nirB基因被敲除时,溶藻弧菌对铵盐的利用也受到影响,推测nirB基因缺失可能会导致其氮代谢过程中的谷氨酰胺合成酶和谷氨酸合酶作用底物可能减少。
硝酸盐培养基中,所有菌株的生长能力较在M9培养基的生长能力下降。这有可能是由于溶藻弧菌不能直接利用硝酸盐,需要将硝酸盐异化还原为铵盐才能被利用,而这个异化过程需要消耗能量,从而导致生长能力下降[14]。同时,有报道称nirB基因参与硝酸盐呼吸[15],所以当nirB基因缺失时,利用硝酸盐的能力通常会下降。在溶藻弧菌中,nirB基因编码的同化亚硝酸还原酶参与氮循环过程中,与硝酸盐异化还原为铵(DNRA)过程存在密切的关系,并在这一过程中起关键作用。有报道显示,硝酸盐虽然不是亚硝酸还原酶作用的直接底物,但可以作为诱导剂促进nirB基因功能的表达,甚至在大肠杆菌中是比亚硝酸盐更有效的诱导剂[16]。在硝酸盐培养基中ΔnirB2缺失株的生长能力变化不大,但ΔnirB1和ΔnirB12缺失株生长明显受到抑制,这说明在溶藻弧菌中,nirB1基因在硝酸盐转化为亚硝酸盐过程中起着重要的作用。ΔnirB1和ΔnirB12缺失株虽然生长能力下降,但仍能缓慢生长,而有报道结核分枝杆菌的 nirB 突变体在硝酸盐和亚硝酸盐上均未生长[17],说明在溶藻弧菌中编码同化亚硝酸还原酶的过程可能存在其他补偿机制。现有海洋微生物研究表明弧菌属是最常见的硝酸盐还原菌,其次是肠杆菌科,弧菌能够在有限的条件下积累铵[18]。这为溶藻弧菌ΔnirB1、ΔnirB2缺失株在以硝酸盐为唯一氮源的培养基中能生长提供依据。nirB基因虽然不直接参与到硝酸盐的利用,但在氮循环中,NO3-会转变成NO2-,nirB编码的同化亚硝酸还原酶直接参与NO2-还原为铵盐(NH4+)的过程中[4],且起重要的作用,所以当溶藻弧菌nirB基因缺失,其编码的同化亚硝酸还原酶受到影响,利用硝酸盐能力下降,生长能力变弱。
在铵盐和硝酸盐混合培养基中菌株的生长能力较在铵盐培养基中培养时下降。有报道在一些海洋生物如某些藻类,在同时向培养物中加入硝酸盐和铵盐后,与单独添加硝酸盐和铵盐相比,硝酸盐和铵盐的吸收率均有所降低[19]。在本实验中虽然没有直接测定硝酸盐和铵盐的吸收率,但从其生长曲线推测,当溶藻弧菌ΔnirB2缺失株培养在同时含铵盐和硝酸盐的培养基中,同样会使得其与单独添加硝酸盐和铵盐的培养基相比,硝酸盐和铵盐的吸收率会有所降低,溶藻弧菌中的nirB2基因影响其同时吸收硝酸盐和铵盐的的能力。在硝酸盐异化成氨的过程中,菌株还原硝酸盐时会先积累亚硝酸盐[20],亚硝酸盐通过亚硝酸还原酶生成铵[21-22],供菌株的生长吸收。溶藻弧菌株利用硝酸盐的过程中需要将NO3-转变成NO2-,结合ΔnirB1缺失株的生长能力在铵盐和硝酸盐混合培养基中基本恢复到WT株状态,推测nirB1基因在溶藻弧菌的NO3-转变成NO2-的过程中,起着关键的作用。
在含亚硝酸盐培养基中,溶藻弧菌在亚硝酸质量浓度为1.0 和0.5 g·L−1的培养基中,均不能正常生长,说明nirB基因虽然对亚硝酸盐的利用起着重要的作用,但也存在一定的阈值。高浓度的亚硝酸盐抑制生物的生长,甚至加速生物的死亡[23]。本研究结果表明,在外源添加硝酸盐的情况下,野生株的生长也受到了明显抑制,根据本研究数据和分析,推测外源添加硝酸盐后野生株生长受抑制可能是因为添加的氮源浓度过高,产生了抑菌效果以及亚硝酸盐(NO2−)的毒性积累。有相关报道发酵乳杆菌 RC4 中,nirB 活性在 0.3 g·L−1 亚硝酸盐浓度下达到峰值[24]。而溶藻弧菌在1.0、0.5、0.25 g·L−1亚硝酸盐浓度中,只有0.25 g·L−1亚硝酸盐浓度下其体内的nirB活性足够支持溶藻弧菌的生长,此时的生长曲线对照更能说明nirB基因在溶藻弧菌中的功能。nirB1、nirB2和nirB12基因的缺失对细胞生长产生了显著的负面影响,且不同基因缺失的影响程度存在差异。
ΔnirB1、ΔnirB2缺失株在硝酸盐培养基和含亚硝酸盐培养基中中的生长优势刚好相反。在含亚硝酸盐的培养基中,ΔnirB1缺失株的生长趋势明显优于ΔnirB2缺失株的生长趋势。说明nirB2基因在溶藻弧菌利用亚硝酸盐的过程中起更重要作用。但nirB2缺失株分别在亚硝酸盐质量浓度为0.25 g·L−1的培养基中和铵盐质量浓度为1 g·L−1、亚硝酸质量浓度为0.25 g·L−1的混合培养基中的生长曲线却有着明显的差异,而这两种培养基唯一的区别就是是否含有铵盐,说明铵盐的存在会影响溶藻弧菌对亚硝酸盐的利用。有报道在铜绿假单胞菌(Pseudomonas aeruginosa)中,ΔnirB突变体中,亚硝酸盐的消耗几乎被消除[25],溶藻弧菌ΔnirB2缺失株在0.25 g·L−1亚硝酸盐培养基中,仍能正常生长。但在铵盐和亚硝酸盐浓度分别为1.0 g·L−1和0.25 g·L−1的混合液体培养基生长能力几乎被消除,而培养铜绿假单胞菌ΔnirB突变体的培养基中同样含有铵盐,因此推测铵盐和亚硝酸盐之间可能存在竞争关系,这种竞争关系也发现在需要同时利用铵离子和亚硝酸盐作为氮源的微生物中[26]。在铜绿假单胞菌ΔnirB缺失株中NO和NO3−的消耗不受影响,仅NO2−的消耗受影响。溶藻弧菌ΔnirB2缺失株在铵盐和亚硝酸盐质量浓度分别为1.0 和0.25 g·L−1的混合液体培养基中生长受到明显的抑制,但在硝酸盐培养基中的生长基本不受影响,因此推测溶藻弧菌中nirB2基因的功能与铜绿假单胞菌nirB基因功能更相似,溶藻弧菌利用亚硝酸盐过程中nirB2基因较nirB1基因起着更重要的作用。
在硝酸盐肉汤培养基的鉴定实验中。加入硝酸盐还原试剂后,只有WT野生ΔnirB2缺失株硝酸盐肉汤培养基变红,且ΔnirB2缺失株硝酸盐肉汤培养基红色明显比WT野生株硝酸盐肉汤培养基深,说明ΔnirB2缺失株在利用亚硝酸盐的过程中受到阻碍,与上述讨论推测的结果——nirB2基因在溶藻弧菌利用亚硝酸盐过程中起着重要的作用。ΔnirB1、ΔnirB12缺失株硝酸盐肉汤培养基在分别加入硝酸盐还原试剂盒中的溶液A和溶液B各2-3滴后培养基不变红,说明培养基中不存在亚硝酸盐,加入锌条后,溶液变红,说明培养基中仍存在硝酸盐,ΔnirB1、ΔnirB12缺失株不可以利用硝酸盐转化成亚硝酸盐或转化的亚硝酸盐被完全利用或将硝酸盐转化成其他含氮物质。ΔnirB1、ΔnirB12缺失株在该鉴定实验与上述讨论结果体验保持一致——nirB1基因在溶藻弧菌利用硝酸盐转化成亚硝酸盐过程中起着重要的作用。
各菌株在铵盐/硝酸盐培养基中NH4+、NO2−的测定实验结果 ,进一步确认了nirB基因的功能。铵盐培养基中的实验结果分析,所有菌株均能利用NH4+作为氮源,且未检测到NO2−积累,敲除nirB1基因后,溶藻弧菌利用铵盐的能力有所增强,结果表明nirB1基因具有部分负调控铵盐利用的能力。而敲除nirB2基因后,菌株的铵盐利用能力显著下降,表明nirB2基因的存在可以促进铵盐的利用;硝酸盐培养基中的实验结果分析,说明其缺失导致硝酸盐利用障碍。nirB1是编码硝酸盐还原酶或硝酸盐还原途径中的关键酶,负责将NO3−还原为NO2−。ΔnirB2 在硝酸盐培养基中能生长,但NO2−积累量显著高于野生株,且NH4+生成增加,表明其缺失导致NO2−代谢受阻,可能通过替代途径生成并利用更多的NH4+。
-
目前对溶藻弧菌中的nirB基因的功能研究已经取得了一部分的进展,但对其利用铵盐、硝酸盐以及亚硝酸盐的分子机制仍尚未清楚。现有研究表明在部分菌株中,其体内的亚硝酸还原酶除了与自身的氮代谢途径有关,还与其生物膜的形成能力,运动能力[27-28]有关。氮元素是生物体生存生长不可或缺的,从本研究结果可以明显看出,虽然在KEGG代谢通路图中nirB基因的编码蛋白(EC1.7.1.15)与亚硝酸盐代谢直接相关,但在本研究发现nirB1基因是硝酸盐利用的必须基因,且nirB1基因具有部分负调控铵盐利用的能力;nirB2 基因促进NO2−的利用但不必需,其缺失还可能影响溶藻弧菌对的NH4+利用或激活替代途径致铵盐含量增加,或因基因冗余补偿效率低而积累代谢产物。本研究为进一步理解溶藻弧菌中nirB基因的功能及其在氮代谢中的作用提供了研究基础。
Functional analysis of the nirB gene in Vibrio alginolyticus
DOI: 10.15886/j.cnki.rdswxb.20250156
- Received Date: 2025-10-30
- Accepted Date: 2026-01-13
- Rev Recd Date: 2025-12-16
-
Key words:
- Vibrio alginolyticus /
- nirB /
- ammonium /
- nitrate /
- nitrite
Abstract: Vibrio alginolyticus, a conditionally pathogenic bacterium widely present in marine environments, can utilize various inorganic nitrogen sources such as ammonium, nitrate, and nitrite for growth, causing significant economic losses in the marine aquaculture industry. The nirB gene encodes nitrite reductase, which plays an important role in bacterial nitrogen metabolism and environmental adaptation. An attempt was made to analyze the function of the nirB gene in V. alginolyticus during the utilization of inorganic nitrogen sources. Two nirB gene-related knockout strains of V. alginolyticus were constructed: a nirB1 deletion strain (ΔnirB1) and a nirB2 deletion strain (ΔnirB2), and a double deletion strain lacking both nirB1 and nirB2 (ΔnirB12) was also constructed. These strains were cultured in different types of inorganic nitrogen media to observe their growth. The results showed that the nirB gene promotes the utilization of ammonium and nitrate in V. alginolyticus, with the nirB1 gene playing a key role in the conversion of nitrate to nitrite. In nitrite media, deletion of the nirB gene significantly inhibited the growth of V. alginolyticus, indicating that the gene also plays an important role in nitrite utilization, and the nirB2 gene has a more critical function in this process. Moreover, the presence of ammonium was also found to affect the utilization of nitrite by V. alginolyticus, suggesting a possible competitive relationship. All the results provide a foundation for further understanding of the function of the nirB gene in V. alginolyticus and its role in nitrogen metabolism.
| Citation: | Liang Yuanying, Yang Yong, Xie Zhenyu, Long Hao. Functional analysis of the nirB gene in Vibrio alginolyticus[J]. Journal of Tropical Biology. doi: 10.15886/j.cnki.rdswxb.20250156 |

DownLoad:
DownLoad:












